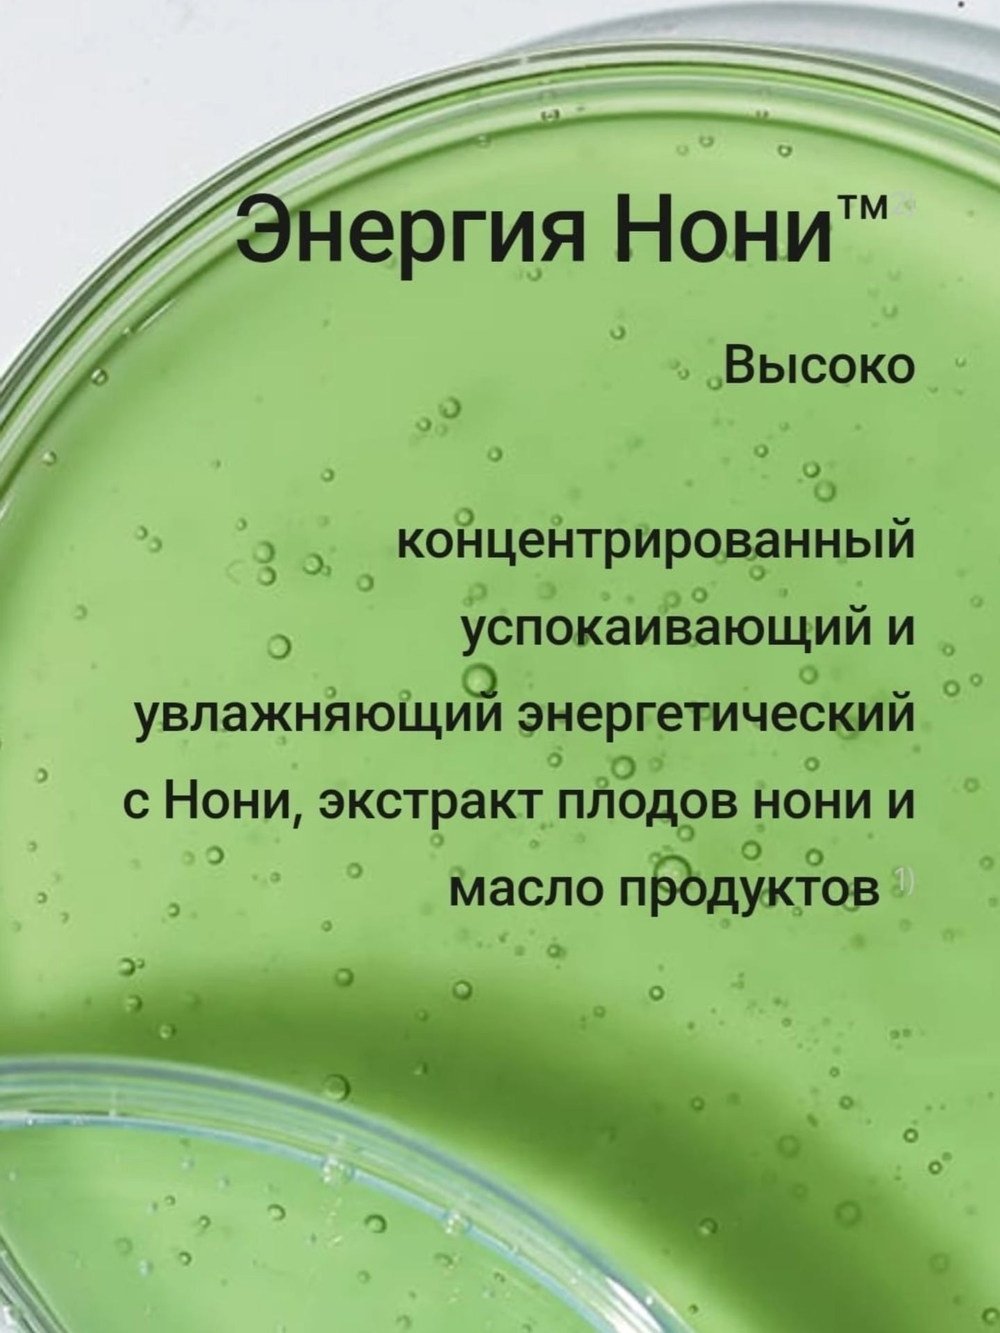
Celimax Восстанавливающий крем с экстрактом нони The Real Noni Energy Repair Cream, 10 мл

Крем Celimax The Real Noni Energy Repair Cream восстанавливает тонкую кожу, успокаивает и смягчает, ускоряет восстановление, устраняет шелушение и сухость, снимает воспаление, повышает упругость и эластичность.
Продукт повышает натуральный увлажняющий фактор (NMF) и укрепляет естественный гидролипидный барьер, который препятствует испарению влаги и удерживает питательные вещества в эпидермисе: кожа становится гладкой, плотной и сияющей.
Гипоаллергенная формула с pH 5-6,5 не провоцирует раздражение, подходит даже чувствительной коже. Плотная кремовая текстура легко распределяется и отлично впитывается, не утяжеляет, может использоваться перед нанесением макияжа.
Главный компонент — экстракт нони — тропический суперфуд, насыщенный витаминами и минералами, который интенсивно питает и успокаивает, снижает чувствительность к внешним раздражителям, блокирует очаги воспаления и оказывает антивозрастной эффект, защищая клетки от разрушения свободными радикалами.
Дополнительные действующие компоненты:
- Аденозин — антивозрастной актив, стимулирующий выработку коллагена и повышающий упругость и гладкость.
- Церамиды укрепляют гидролипидную мантию, встраиваясь в неё, за счёт чего препятствуют испарению влаги и удерживают полезные компоненты в эпидермисе.
- Ниацинамид (витамин B3) устраняет жирный блеск и регулирует себовыделение, осветляет пигментацию и препятствует появлению пигментных пятен, стимулирует выработку коллагена.
- Масло ши питает, предотвращает появление морщин, смягчает и запускает процесс регенерации.
- Масло листьев розмарина ускоряет регенерацию, оказывает обеззараживающее действие, улучшает микроциркуляцию и тонизирует.
Подходит для нормальной, комбинированной, сухой и чувствительной кожи.
Способ применения: нанесите крем на лицо после очищения, тонизирования и использования сыворотки. Можно нанести средство в несколько слоёв в качестве ночной маски, либо смешать с тональным средством в соотношении 1:4.
Water, Glycerin, Methylpropanediol, Methyl Trimethicone, Hydrogenated Poly(C6-14 Olefin), Neopentyl Glycol Diheptanoate, 1,2-Hexanediol, Niacinamide, Butyrospermum Parkii (Shea) Butter, Caprylic/Capric Triglyceride, Trehalose, Polyglyceryl-3 Methylglucose Distearate, Dimethicone/Vinyl Dimethicone Crosspolymer, Cetyl Alcohol, Glyceryl Stearate SE, Morinda Citrifolia Seed Oil, Butylene Glycol, Morinda Citrifolia Fruit Extract, Carbomer, Palmitic Acid, Stearic Acid, Behenyl Alcohol, Tromethamine, Dipropylene Glycol, Cetearyl Alcohol, Hydrogenated Lecithin, Laminaria Japonica Extract, Eclipta Prostrata Leaf Extract, Ethylhexylglycerin, Rosmarinus Officinalis (Rosemary) Leaf Oil, Polyglyceryl-10 Myristate, Melia Azadirachta Leaf Extract, Propanediol, Adenosine, Sodium Stearoyl Glutamate, Malt Extract, Fructooligosaccharides, Melia Azadirachta Flower Extract, Cholesterol, Beta-Glucan, Sodium Hyaluronate, Acmella Oleracea Extract, Ceramide NP, Ficus Carica (Fig) Fruit Extract, Centella Asiatica Extract, Hydrolyzed Hyaluronic Acid, Myristic Acid, Arginine, Tocopherol, Phenoxyethanol, Aloe Barbadensis Leaf Extract, Althaea Rosea Flower Extract